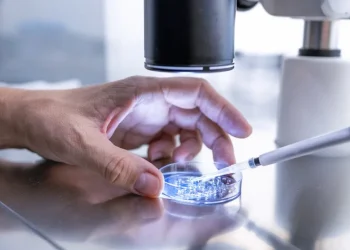
US halts IVF services after court ruling

Kwara State university campus in Osi ready for first lectures
November 18, 2024
Police in Kano urges caution as Muslims begin Ramadan
March 11, 2024
Is UCH in darkness: Need for responsible journalism!
February 9, 2025
Police ncover Abduction Scam, Arrest Eight in Ogun
June 8, 2026
Four die as Warri-Itakpe train derails again
June 8, 2026
Oyo government demolishes kidnappers’ den at Aiyegun
June 8, 2026